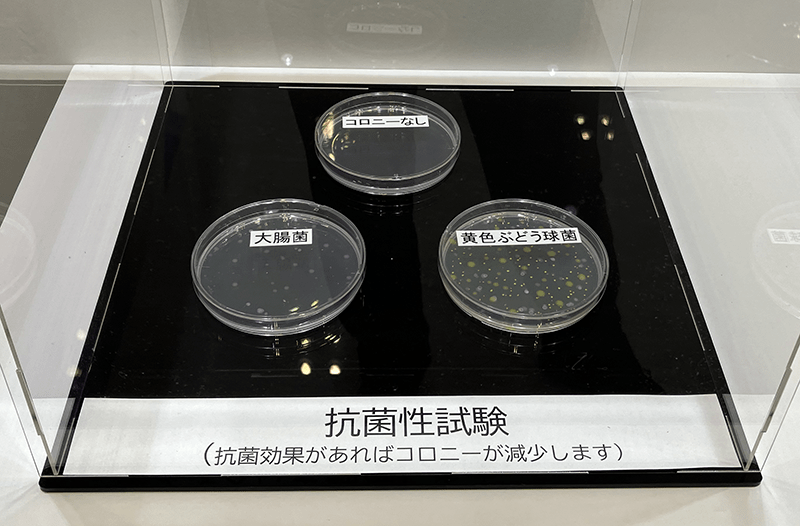

- 一般財団法人カケンテストセンター
- お知らせ
- その他
- 第2回感染対策EXPO東京 出展レポート
第2回感染対策EXPO東京 出展レポート
2022.10.19

当センターは、2022年10月12日(水)~14日(金)の3日間、幕張メッセで開催された「第2回感染対策EXPO東京」に出展しました。

新型コロナウイルス感染症の拡大から、感染対策製品が脚光を浴び、様々な商品が市場にあふれています。当センターでは長い間、感染対策製品のエビデンスとなる試験を実施しており、今回、業界や消費者に対して安全・安心を届ける活動の一環として感染対策EXPO東京に出展いたしました。
感染対策EXPO東京を含む、第5回医療・介護・薬局Week[東京](通称:メディカル ジャパン)では、1万3000人強(速報値)が来場され、当センターのブースにも多数の方にご来場いただきました。
|
 |
|
| 抗菌性試験の紹介として、黄色ブドウ球菌や大腸菌の増殖の様子をシャーレを用いて疑似的に展示しました。 | マスクの人工血液バリア性試験の紹介として、マスクに人工血液を噴射し、マスク裏側に浸透したものと浸透しなかったものを展示しました。 | |
 |
||
| マスクの花粉粒子捕集効率試験の紹介として、疑似花粉粒子をフィルターで捕集した実物を説明パネルを用いて展示しました。 |
|
|
 |
|
| ブースの様子 | ||
当センターブースに足を運んでいただきましたお客様、誠に厚く御礼申し上げます。









